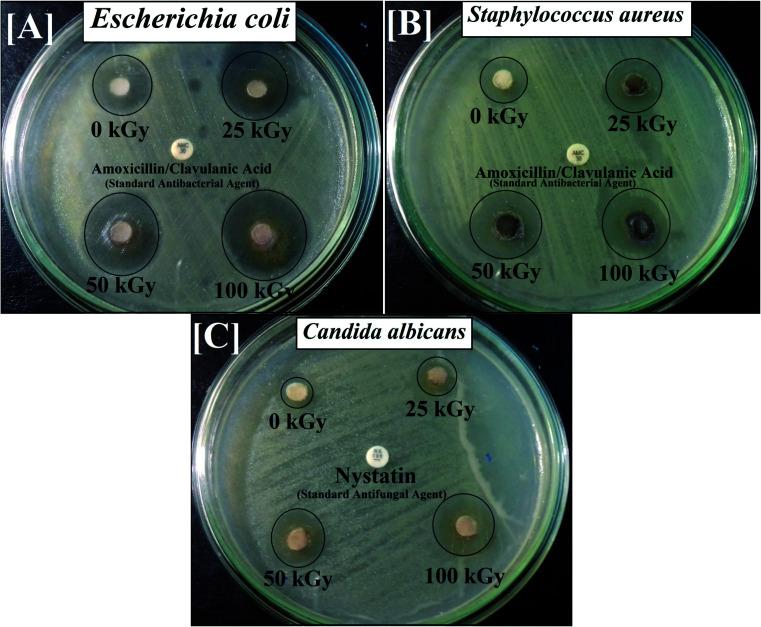
https://cdn.ncbi.nlm.nih.gov/pmc/blobs/75c8/9049020/512a384e45d7/c9ra10505k-f4.jpg

γ辐照的CoNiFeO/SiO/TiO(= 0.9)纳米复合材料用于去除吡啶和消毒致病细菌/真菌的光催化及抗菌应用的优点:对废水处理的意义
Merits of photocatalytic and antimicrobial applications of gamma-irradiated Co Ni FeO/SiO/TiO; = 0.9 nanocomposite for pyridine removal and pathogenic bacteria/fungi disinfection: implication for wastewater treatment.
作者信息
El-Sayyad Gharieb S, Abd Elkodous M, El-Khawaga Ahmed M, Elsayed Mohamed A, El-Batal Ahmed I, Gobara Mohamed
机构信息
Drug Microbiology Laboratory, Drug Radiation Research Department, National Center for Radiation Research and Technology (NCRRT), Egyptian Atomic Energy Authority Cairo Egypt
Department of Electrical and Electronic Information Engineering, Toyohashi University of Technology Toyohashi Aichi 441-8580 Japan
出版信息
RSC Adv. 2020 Feb 3;10(9):5241-5259. doi: 10.1039/c9ra10505k. eCollection 2020 Jan 29.
In this paper, we report a layer-by-layer approach for the preparation of a concentric recyclable composite (Co Ni FeO/SiO/TiO; = 0.9) designed for wastewater treatment. The prepared composite was investigated by X-ray diffraction spectroscopy, high-resolution transmission electron microscopy and scanning electron microscopy (SEM) supported with energy dispersive X-ray (EDX) spectroscopy to analyze crystallinity, average particle size, morphology and elemental composition, respectively. The antimicrobial activities of the prepared composite have been investigated against multi-drug-resistant bacteria and pathogenic fungi using a variety of experiments, such as zone of inhibition, minimum inhibitory concentration, biofilm formation and SEM with EDX analysis of the treated bacterial cells. In addition, the effects of gamma irradiation (with different doses) and UV irradiation on the antibacterial abilities of the prepared composite have been evaluated. Moreover, the effect of gamma irradiation on the crystallite size of the prepared composite has been studied under varying doses of radiation (25 kGy, 50 kGy and 100 kGy). Finally, the photocatalytic efficiency of the prepared composite was tested for halogen-lamp-assisted removal of pyridine (artificial wastewater). Various parameters affecting the efficiency of the photocatalytic degradation, such as photocatalyst dose, pyridine concentration, pH, point of zero charge and the presence of hydrogen peroxide, have been studied. Our results show that the synthesized composite has a well-crystallized semi-spherical morphology with an average particle size of 125.84 nm. In addition, it possesses a high degree of purity, as revealed by EDX elemental analysis. Interestingly, the prepared composite showed promising antibacterial abilities against almost all the tested pathogenic bacteria and unicellular fungi, and this was further improved after gamma and UV irradiation. Finally, the prepared composite was very efficient in the light-assisted degradation of pyridine and its degradation efficiency can be tuned based on various experimental parameters. This work provides a revolutionary nanomaterial-based solution for the global water shortage and water contamination by offering a new wastewater treatment technique that is recyclable, cost effective and has an acceptable time and quality of water.
在本文中,我们报告了一种用于制备同心可回收复合材料(CoNiFeO/SiO/TiO;= 0.9)的逐层方法,该复合材料专为废水处理而设计。通过X射线衍射光谱、高分辨率透射电子显微镜和扫描电子显微镜(SEM)并辅以能量色散X射线(EDX)光谱对制备的复合材料进行了研究,分别分析其结晶度、平均粒径、形态和元素组成。使用多种实验,如抑菌圈、最低抑菌浓度、生物膜形成以及对处理后的细菌细胞进行带有EDX分析的SEM,研究了制备的复合材料对多重耐药细菌和致病真菌的抗菌活性。此外,还评估了γ射线辐照(不同剂量)和紫外线辐照对制备的复合材料抗菌能力的影响。而且,研究了在不同辐射剂量(25 kGy、50 kGy和100 kGy)下γ射线辐照对制备的复合材料微晶尺寸的影响。最后,测试了制备的复合材料在卤素灯辅助下去除吡啶(人工废水)的光催化效率。研究了影响光催化降解效率的各种参数,如光催化剂剂量、吡啶浓度、pH值、零电荷点和过氧化氢的存在。我们的结果表明,合成的复合材料具有结晶良好的半球形形态,平均粒径为125.84 nm。此外,EDX元素分析表明其具有高度纯度。有趣的是,制备的复合材料对几乎所有测试的致病细菌和单细胞真菌都显示出有前景的抗菌能力,并且在γ射线和紫外线辐照后进一步提高。最后,制备的复合材料在光辅助降解吡啶方面非常有效,其降解效率可根据各种实验参数进行调节。这项工作通过提供一种可回收、成本效益高且具有可接受的水时间和质量的新型废水处理技术,为全球水资源短缺和水污染问题提供了一种基于纳米材料的革命性解决方案。